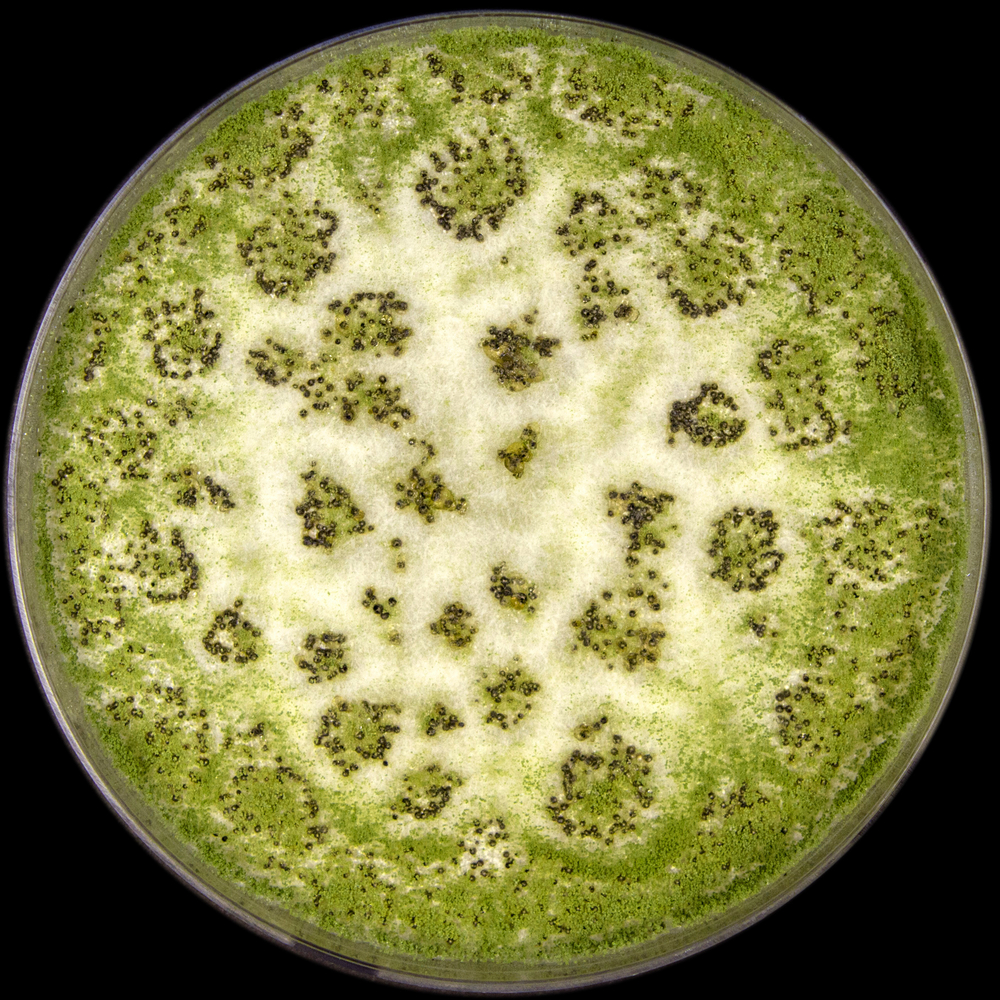

Застрашени ли са зърнените култури в Европа от нови гъбични токсини в резултат на климатичните промени?
Микроскопичните гъбички, известни още като плесени, образуват голям набор от токсини, наречени микотоксини. Гъбичките и техните токсини са широко разпространени в природата и замърсяват хранителните продукти, основно зърнените култури. Попадайки в организма на хората и животните, те предизвикват тежки заболявания и са сериозен проблем за общественото здраве. Сред най-опасните микотоксини се откроява групата на афлатоксините. За тяхното образуване са необходими високи температури, поради което те се срещат предимно в страните с тропически и субтропически климат. В резултат на климатичните промени и в частност глобалното затопляне средните годишни температури в Европа се увеличават с всяка измината година и условията на стария континент стават много подходящи за образуването на опасните афлатоксини в зърнени култури и други хранителни продукти. Ако затоплянето продължи с тези темпове, афлатоксините ще се превърнат в сериозен проблем за здравето на хората и селскостопанските животни.
Микроскопичните гъбички попадат в зърнените култури от почвата и при подходяща температура и влажност на въздуха образуват в тях токсични продукти, наречени микотоксини. Тези токсини навлизат в организма на човека с храната и поразяват различни органи и системи, причинявайки сериозни заболявания. Най-вредни от гледна точка на общественото здраве са афлатоксините, които се образуват от гъбички, принадлежащи към род Aspergillus (фиг. 1).
Гъбичките от този род са широко разпространени в природата и се изолират често от почвите, особено от тези в тропическите и субтропическите области, също така от фуражи и гниещи растения, от семена и зърна на различни култури и от различни видове хранителни продукти.
Тези гъбички могат да поразяват селскостопанските култури още на полето, по време на прибиране на реколтата и нейното съхраняване. Повечето видове Aspergillus не са типични за ширини над 45°, поради което не се срещат в зърнените култури, отглеждани в Европа.
Афлатоксин В1 е най-токсичен и най-разпространен от групата на афлатоксините. Той има широк спектър на поразяване и токсични ефекти: остри и хронични токсикологични въздействия.
Чувствителността към афлатоксините е най-голяма при младите хора и децата,
тя е причина за 5 милиона смъртни случая при деца на възраст до 5 години в страни с ограничени хранителни ресурси. Афлатоксините поразяват основно черния дроб, където се наблюдава некроза, цироза и ракови изменения и това води до сериозни последствия за здравето. Международната агенция за изучаване на рака (IARC) поставя афлатоксин В1 в група 1 на канцерогените, което означава, че може да предизвика рак при хората.
Афлатоксините имат важно значение и в икономически план, поради загубите, които нанасят на селското стопанство. Организацията за прехрана и земеделие (FAO) е изчислила, че 25% от реколтите в света са засегнати от микотоксините, от които най-известни са афлатоксините (фиг. 2).
Тази група микотоксини се среща в зърнените култури, ядките, сушените плодове, подправките, млякото и млечните продукти. Тяхното съдържание в храните и фуражите е регламентирано в 99 страни по света. Афлатоксините се откриват често в храни и хранителни продукти, отглеждани и произведени в Африка и Азия поради благоприятните климатични и други параметри, като: високи температури, висока влажност, липса на аерация при съхранението, увреждане на храните от инсекти и гризачи, способстващи разпространението на гъбните спори. Царевицата и фъстъците са културите най-засегнати от гъбичките Aspergillus и те са едни от най-консумираните култури в Азия и Африка.
По-високи нива на токсините се откриват през летните месеци и по-ниски – през зимните.
Мусонните периоди са също изключително благоприятни за растежа на гъбичките Aspergillus и продукцията на афлатоксините. Оптималната за растежа влажност на въздуха е 97-99%, а оптималната температура – 25-30°С.
Съгласно Green Paper на Европейската комисия върху климатичните промени в Европа «температурата в Европа през последния век се е повишила с почти 1°C, т.е. по-бързо от средните стойности в света. Валежите и снеговалежите значително са се увеличили в Северна Европа, докато в Южна Европа се наблюдава все по-често суша». В анексите към Green Paper се посочват промените, които ще настъпят в Европа до края на 21 век, ако не се вземат спешни мерки за подобряване на ситуацията с парниковите газове. Съгласно този доклад
средната глобална температура в Европа ще се увеличи с 3,4°С до края на този век.
В Южна и Югоизточна Европа (Португалия, Испания, Южна Франция, Италия, Словения, Гърция, Малта, Кипър, България и Южна Румъния) се прогнозира покачване на средно годишната температура с 4-5°С, а наличието на вода ще се намали особено през лятото. Това ще доведе до:
- намаляване на селскостопанските добиви с 10-30% в много региони,
- суша, горещи вълни,
- деградация на почвата и екосистемата,
- опустиняване.
А сушата и високите температури ще увеличат и нивата на афлатоксините в културите.
Продукцията на афлатоксини от микроскопичните гъбички зависи от:
- климатичните условия (температура и валежи),
- съхранението на културите,
- наличието на микронутриенти,
- увреждането на културите от инсектите и други вредители.
Следователно увеличаване или намаляване на добивите от зърнени култури, и заедно с това промени в микотоксинообразуването, ще се наблюдават с промените в климата, които са от решаващо значение. При високи температури и ниска водна активност, условия, които се наблюдават при суша, гъбичките Aspergillus стават много конкурентни спрямо другите микроскопични гъбички и могат да се превърнат в доминантни гъбни видове в почвата. Тези условия на околната среда стимулират растежа и образуването на афлатоксини, както и активността на инсектите, нападащи културите, което води до отслабване на защитната система на растенията.
В година, когато температурата е с 2-3°С по-висока от нормалната, се откриват високи нива на афлатоксини.
Високата температура обикновено се съчетава със суша, която от своя страна усилва инфектирането на зърната и гъбния растеж. Изследвания показват, че модификации във водната активност и температурата въздействат непосредствено върху гените, отговарящи за растежа и образуването на афлатоксини.
Досега в Европа афлатоксините се разглеждаха като «импортен» проблем и затова се прилага стриктен контрол при вноса на рискови храни, като фъстъци, шам фъстък и царевица. При покачване на температурата до 30°С вследствие на глобалното затопляне, гъбичките Aspergillus ще доминират над другите видове плесени и
афлатоксините от „импортен“ се превръщат в проблем за регионите с умерен климат, в това число и България.
В редица южни европейски страни се открива афлатоксин В1 в местни култури в нива значително надвишаващи нормата. Всички европейски страни, включително и южните, нормално не се характеризират с топло и сухо време през култивацията на зърнените култури. В някои области и години това се случва и тогава гъбичките от род Aspergillus намират подходящи условия за техния растеж и образуване на афлатоксини. През периода 2003 – 2004 г. и по-късно през лятото на 2012 г. в Средиземноморския регион на Европа, като например Северна Италия, се е наблюдавала суша и високи температури, което е довело до значителен растеж на гъбичките Aspergillus и усилена продукция на афлатоксини. В резултат на това в млякото на млекодайните животни, захранвани с такава царевица, е открит афлатоксин М1. През 2012 г. в Сърбия се е наблюдавало продължително горещо и сухо лято и в резултат 69% от пробите царевица са съдържали афлатоксини.
Подобна ситуация е наблюдавана и в Унгария, където нарастването в продукцията на афлатоксини се свързва с климатичните промени и по-специално с дълги периоди на суша и високи температури.
Възможни са следните сценарии относно климатичните промени в Европа и риска от афлатоксини:
1. Висок риск в южните страни, които не са понастоящем основни производители на царевица (Централна и Южна Испания, Централна и Южна Италия, Гърция, Северна и Югоизточна Португалия, България, Албания и Кипър);
2. Нисък и среден риск от афлатоксините в 4 страни, основни производители на царевица (Румъния, Франция, Унгария и Североизточна Италия, всички те осигуряват 73% от общото производство в ЕС);
3. Ниски рискове в северните страни, които днес са в защитната зона спрямо афлатоксините поради климатичните условия в тях,
4. Много нисък риск в Европа за пшеницата и ориза.
С промените в климата се очаква да нарасне количеството на микотоксините в селскостопанските култури и в други хранителни продукти. Ще се увеличи разпространението на „високотемпературните гъбички и микотоксини” като гъбичките Aspergillus и афлатоксините. Субтропическите региони ще станат тропически със съответните промени в профила на микотоксините. През следващите години, в резултат на промяната на климата, микроскопичните гъбички с по-висок температурен оптимум за растеж и микотоксинообразуване (гъбичките от род Aspergillus,) ще доминират в региони, които понастоящем имат по-хладен климат, или ще бъдат по-слабо представени в региони с горещ климат, тъй като температурите стават твърде високи и надвишават техния температурен оптимум. От друга страна, новите горещи и сухи условия в някои региони ще доведат до по-добри условия на съхранение, тъй като ще поддържат реколтите сухи и с това ще ги предпазват от гъбния растеж и образуването на микотоксини.
Автор: Доц. д-р Тери Врабчева / Климатека
Доц. д-р Тери Врабчева, дм е завършила медицина в Санкт Петербург, Русия и след това защитава дисертация в Националния център по обществено здраве и анализи по проблемите на безопасността на храните, където от 2006 г. е доцент. Има специализации в Германия, Франция, Холандия и Италия. Професионалните ѝ интереси са в областта на химическата безопасност на храните. Последните няколко години се занимава с влиянието на климатичните промени върху храните и храненето.
В публикацията са използвани материали от:
- Charmley LL, Trenholm HL, Prelusky DA and Rosenberg A, 1995. Economy losses and decontamination. Natural Toxins, 3, 99-203.
- European Commission, 2007. Adapting to Climate Change in Europe – Options for EU Action. Green Paper from the Commission to the Council, the European Parliament, the European Economic and Social Committee and the Committee of the Regions.
- IARC (International Agency for Research on Cancer), 1993. Monographs on the evaluation of Carcinogenic risks to Humans. Some naturally occurring substances: food items and constituents, heterocyclic aromatic amines and mycotoxins. Editor. World Health Organization Lyon, France, 599 pp.
- Kelly JD, Eaton DL, Guengerich FP and Coulombe RJ, 1997. Aflatoxin B1 activation in human lung. Toxicology and Applied Pharmacology, 144, 88-95.
- Klich MA, 2007. Environmental and developmental factors influencing aflatoxin production by Aspergillus flavus and Aspergillus parasiticus. Mycoscience, 48, 71-80.
- USDA (United States Department of Agriculture), 2006. Grain fungal diseases and Mycotoxin reference. Editor. United States Department of Agriculture, 36 pp.
- Williams JH, Phillips TD, Jolly PE, Stiles JK, Jolly CM, Aggarwal D. 2004. Human aflatoxicosis in developing countries: a review of toxicology, exposure, potential health consequences, and interventions. Am J Clin Nutr, 80, 1106-1122.